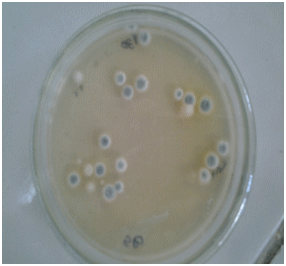

| Livestock Research for Rural Development 31 (3) 2019 | Guide for preparation of papers | LRRD Newsletter | Citation of this paper |
The aim of this study was to evaluate the efficacy of adsorbent based on a combination of clay and essential oils named NPV in vitro and in situ in reducing mycotoxins rate in maize of two experiments. The objective of the first experiment was to evaluate the adsorption of aflatoxins in vitro by five commercial binders and by NPV using an in vitro method that mimes the gastro-intestinal tract of pigs. The results showed that NPV had high adsorption efficiency for aflatoxins. In the second experiment, in situ actions of three adsorbing agents on mycotoxins production as well as the fungal growth in naturally contaminated maize flour were evaluated. A dose-dependent effect of adsorbents inclusion was observed on mycotoxin production. The most important reduction of mycotoxins accumulation was observed with the NPV followed by Mycofix treatments. The results showed that NPV is the most effective adsorbent against fungal growth.
Keywords: ELISA, fungi, mycotoxin binders, mycotoxins, storage
Maize is the most important crop in the world. It is also the basic constituent of livestock feed. However, the production of this highly important crop is prone to several problems related to the presence of insects and molds. Fungal infestation can occur in the field, during growth, but also after maize harvest by certain molds of the genus Fusarium, Aspergillus, Penicillium and Alternaria (Geary et al 2016). When the environmental conditions are favorable, these molds produce mycotoxins, which are secondary metabolites having an acute or chronic toxicity in animals and humans.
Mycotoxins represent a major issue in livestock production, especially for countries with high ambient temperatures and humidity, and that are dependent on importations of maize and soybeans. These conditions facilitate the growth of molds and of mycotoxin production during storage of these raw materials (Befikadu 2014).
One of the most useful approaches to protect animals against the harmful effects of mycotoxin contaminated feed is the use of organic and inorganic adsorbent materials, such as activated clays, or clays mixed with specific enzymes that bind or degrade mycotoxins (Yiannikouris 2004; Schatzmayr et al 2006; Kolosova and Stroka 2011). However, despite the use of these products, the problem of mycotoxin contamination is still very common, especially in poultry farms, causing mortality, morbidity, and significant losses in zootechnical parameters (Murugesan et al 2015), as well as the risk of finding residues of mycotoxins in derivative products (Alshannaq and Yu 2017).
In this context, we decided to evaluate the action of an innovative product developed in our laboratory and manufactured by the company LIAV (Fez, Morocco). This product, called NPV contains activated Moroccan clay intercalated by essential oils. This intercalation aims to prevent the oils evaporating, and to increase the d-spacings of clays, in order to improve their ability to fix the mycotoxins.
In our research, four families of mycotoxins were studied. They are the most frequently identified mycotoxins in maize (Udomkun et al 2017). These mycotoxins are either produced in the field by Fusarium such as fumonisins and deoxynivalenol (DON) and T-2 toxin or are produced during storage by Aspergillus and Penicillium such as aflatoxins (Yiannikouris and Jouany 2002).
The first experiment aimed to evaluate in vitro the capacity of several commercial clay-based products (Stevensite, calcium bentonite, Calibrin A and Z, Mycofix and NPV) for binding aflatoxins in a system that mimics the digestive process in pigs; and second, to evaluate in situ the ability of NPV, Mycofix and a mixture of two clays to inhibit mold growth, and accumulation of mycotoxins during 8 months of maize flour storage.
Six toxin binder products including calcium bentonite clay (Sajimex, Morocco), Calibrin A and Calibrin Z (Amlan international, USA), Stevensite (Sefrioui, Morocco), Mycofix (Biomin, Austria) and NPV (LIAV, Morocco) were used in this experiment. NPV (Natural Promoter Volaille) is a natural product containing 85% of clay (Stevensite), 12% of thymol and 3% of Oregano essential oil.
The standard solution of aflatoxin in acetonitrile (Romer Labs Diagnostic GmbH, Tulln, Austria) was diluted to 10 ng ml-1 using distilled water. The quantification range of Enzyme-Linked Immunosorbent Assay (ELISA) kit was used for analysis of total aflatoxin the range from 1 to 20 ng ml-1.
The adsorption method of Boisen and Fernández (1997) modified by Kong et al (2014) was used. This model simulated in vivo conditions of the gastrointestinal tract of pigs for the total aflatoxin adsorption. Each sample consisted of 2.5 ml of phosphate buffer (0.1 M, pH 6.0) and 0.5% suspension of each sequestering agent was transferred to 50 ml conical tubes and 5 ml of diluted mycotoxin standard solution was added. For the control treatment, 5 ml of phosphate buffer was added. The pH was adjusted to pH 2.0 by adding 300 μl 1M HCl for simulating pH in the stomach. Then each sample was incubated for 2 h in shaking incubator at 39°C. The incubation of samples was conducted in triplicates of each sequestering agent. After 2 h incubation, 1 ml of phosphate buffer (0.2 M, pH 6.8) was added to the conical tube. For simulating the conditions in the small intestine, 300 μL of 1 M NaOH was also added and incubated at pH 6.8 for 4 h. After incubation, the mixture was centrifuged and the supernatant was obtained for analysis of residual unbound aflatoxins. The AgraQuant® total Aflatoxin (COKAQ1100) ELISA test kits (Romer Labs Inc., Singapore) were used to detect the residual unbound total aflatoxin concentration. The adsorption percentage of total aflatoxin by sequestering agents was calculated (Kong et al 2014).
Materials
The maize used in this study was purchased from Cargill, Morocco. It is destined for animal feed. The maize was ground to a fine powder able to pass through a 20-mesh sieve.
Adsorbents
Three toxin binder products: Mycofix, NPV and a mixture of two Moroccan clays (calcium bentonite and stevensite) were used. Storage experiment The effects of Mycofix, NPV and a mixture of non-activated clays on mycotoxin production and on fungal growth were tested in maize flour. Experimental treatments were:
The additives were applied in concentrations of 0, 1, 2 and 4 g per kg of maize flour. There were three replicates of each treatment.
Each batch was mixed for 10 minutes in an industrial mixer. The bagged samples were then stored at 25°C and 18% moisture content for 8 months. Sampling of maize for mycotoxin analysis was done before storage and eight months after storage.
Maize flour (10g) was homogenized with sterile distilled water (90ml) for 30 min on a horizontal shaker. Then the content of the flasks was filtered in sterile conditions, and the obtained suspension was used to prepare a ten-fold dilution series. Sabouraud chloramphenicol agar was used to enumerate the population densities of fungi from each sample at day 0 (before treatment), and 8 months after the maize flour was treated. The results of mycological analysis were presented as the number of CFU in 1g of maize flour (CFU g-1).
The analyses of mycotoxins were carried out using enzyme-linked immunosorbent assay (ELISA) kits. Commercial ELISA kits were purchased from Romer Labs Singapore Pte Ltd.: AgraQuant® total Aflatoxin (COKAQ1100), AgraQuant® total Fumonisin (COKAQ3048), AgraQuant® Deoxynivalenol (COKAQ4000) and AgraQuant® T-2 toxin (COKAQ6000). The samples were prepared and analyzed according to the instructions provided by the kits (Romer Labs® method, PI-000051-1, PI-000094-1, PI-000082-1, PI-000083-1).
Statistical analysis of the data was performed with one-way analysis of variance (ANOVA) followed by Tukey’s test) (Graph Pad Prism, version 5.03).
Evaluation of six mycotoxin-sequestering agents for aflatoxins adsorption The residual quantity of unbound aflatoxins was greater for calcium bentonite and Calibrin Z treatments than for the rest of the sequestering products (Table 1). The sequestering ability of aflatoxin by the NPV product was greater than that of Calibrin Z and calcium bentonite.
| Table 1. In vitro adsorption of Aflatoxins by various sequestering agents | ||
|
Sequestering agent |
Aflatoxin, ng/ml |
Adsorption, % |
| Initial value | 10.0 | |
| Control | 9.95a | |
| Calcium bentonite | 2.80b | 71.8 |
| Stevensite | 1.38ce | 86.1 |
| Calibrin A | 1.16ce | 88.3 |
| Calibrin Z | 1.64bc | 83.5 |
| NPV | 0.13de | 98.7 |
| Mycofix | 0.67ce | 93.3 |
| SEM | 0.14 | |
| p | <0.0001 | |
| abcde Means with different letters differ at p< 0.05 | ||
For the untreated control, there was a pronounced increase in fungal growth by the end of the incubation period reaching a maximum of 5 × 108 CFU/g (Table 2).
| Table 2. Effect of NPV, Mycofix and non-activated clays on total fungal populations of maize after 8 months storage |
|
|
Fungal population, CFUg -1 |
|
| Control | 5 × 108a |
| NPV | |
| 1 g kg-1 | 5.03 × 105d |
| 2 g kg-1 | 2.0 × 105d |
| 4 g kg-11 | 9 × 103d |
| Mycofix | |
| 1 g kg-1 | 1.4 × 107c |
| 2 g kg-1 | 1.2 × 107c |
| 4 g kg-1 | 1 × 107c |
| Non-activated clay | |
| 1 g kg-1 | 6.9 × 107b |
| 2 g kg-1 | 5.98 × 107b |
| 4 g kg-1 | 5.7 ×107b |
| SEM | 40.8 |
| p | <0.0001 |
| abc Means with different letters differ at p < 0.05 | |
Fungal growth (Plate 11) on all treatments was noticeably lower than for the control. It was higher in the maize flour treated with 4 g kg-1 of Mycofix and non-activated clays than in NPV. The most effective treatment was the NPV which led to a significant decrease of total fungal population to 9 × 103 CFU g-1.
|
 |
| Plate 1. Aspect of fungal growth on Sabouraud medium | |
Development of mycotoxin production of naturally contaminated maize flour after 8 months storage at 25 °C At day 0, before storage, the concentration of mycotoxins was less than the maximum tolerated levels of mycotoxins in foodstuffs. After 8 months of storage at 25 °C, the concentration of aflatoxins, T-2 toxin, DON and fumonisins had all increased (Table 3).
| Table 3. Development of mycotoxins in maize flour after 8 months storage at 25°C | ||||
|
Mycotoxin concentration |
Aaflatoxin (ppb) |
Fumonisin (ppm) |
DON (ppm) |
T-2 Toxin (ppb) |
| 0 | 2.5 | 15.5 | 0.25 | 23.3 |
| 8 | 26.2 | 72.5 | 16.3 | 105 |
| SEM | 0.5 | 1.45 | 0.98 | 1.66 |
| p | <0.0001 | 0.0001 | 0.0002 | 0.0001 |
The capacity of NPV, Mycofix and non-activated clay to inhibit mycotoxin production in the stored maize flour increased in a dose dependent manner (Table 4).
| Table 4. Effect of NPV, Mycofix and Non-activated clays on Aflatoxin, Fumonisins, T-2 toxin and DON production in maize flour stored for 8 months |
||||
| Aflatoxin, ppb |
Fumonsin, ppm |
T-2 toxin, ppb |
DON, ppm |
|
| Control | 26.2a | 72.5 a | 105 a | 16.3 a |
| NPV | ||||
| 1 g kg-1 | 9.52b | 27.2 b | 66.1 b | 0.48 b |
| 2 g kg-1 | 8.42b | 23.6b | 58.2b | 0.46b |
| 4 g kg-1 | 3.14 b | 18.8 b | 48.5 b | 0.40 b |
| Mycofix | ||||
| 1 g kg-1 | 10.6 | 37.2 | 75.4 | 10.8 |
| 2 g kg-1 | 9.24 b | 36.5 b | 71.5 b | 0.54 b |
| 4 g kg-1 | 4.12 b | 30.4 b | 54.9 b | 0.48 b |
| Non- activated calys | ||||
| 1 g kg-1 | 12.6 b | 60.5 a | 86 b | 5.88 b |
| 2 g kg-1 | 10.1 b | 34.3 b | 67.9 b | 0.58 b |
| 4 g kg-1 | 4.42 b | 29.2 b | 69.7 b | 0.46 b |
| SEM | 0.15 | 0.20 | 2.06 | 0.28 |
| p | 0.002 | 0.008 | 0.0023 | 0.016 |
| abc Means with different letters differ at p < 0.05 | ||||
The products used in this study were particularly effective against total aflatoxin production. At 2 g kg-1, there were reductions of 61, 64 and 67% compared to the control for samples treated with non-activated clays, Mycofix and NPV.
The concentration of fumonisins was decreased even at a very low concentration (1 g kg-1) of NPV and Mycofix. Non-activated clays required a higher concentration (2 g kg-1) for a significant reduction of fumonisins production. NPV was particularly effective against fumonisins in the maize flour.
DON production was also reduced in all samples compared to the control. However, the inhibitory effect of NPV was generally higher at lower concentrations. Maximum inhibition compared to the control was obtained with 1 g kg-1 of NPV (97%), while the inhibition of DON production in samples treated with Mycofix and non-activated clays was respectively 34% and 64%.
T-2 toxin production was reduced with increasing NPV and Mycofix concentration. Non-activated clays were less effective than the other treatments. The inhibitory effect of NPV was generally greater than any of the other products.
All the products tested in this experiment showed an aflatoxin adsorption capacity that exceeds 70% (Table 1). These results are in agreement with those obtained by Kong et al (2014).
The superiority of NPV observed in this study compared to other products tested could be explained by the fact that NPV contains a stevensite activated by the intercalation of the MC of EO. This form of activation, which causes an expansion of the d-spacings (from 15.23 to 16.51 Å) measured by X-Ray Diffraction (results not shown) would promote a better fixation of aflatoxins.
Mycofix consists of clays and specific enzymes, which explains its second position before other products containing only non-activated clays. Mycofix is the first-ever adsorbent authorized by the EU an has a potential of aflatoxin reduction above 90% (European Union 2013). Mycofix deactivates aflatoxin with its polar functional group, due to aflatoxin fixation to adsorbing components in Mycofix, with stable binding capacity (Mahmood et al 2011).
Many studies have shown the antifungal effect of essential oils on molds contained in maize (Bluma et al 2008; Mylona 2012; Boudine et al 2016). Bluma and Etcheverry (2008) have shown that the essential oils of clove and thyme inhibit the growth of Aspergillus Flavi and production of aflatoxins in maize seeds after 11 days of incubation. Boukaew et al (2017) showed that the fumigation for 6 h of the maize seeds by essential oils of clove and vatica completely inhibits the growth, sporulation and germination of conidia of Aspergillus during 14 days. This allows us to assume that NPV has both the ability to reduce the activity of water through the clay it contains, and an antifungal action through the compounds in the essential oils.
Our results show that the experimental conditions resulted in rates of mycotoxin contamination at least twice the value tolerated by international standards (European Commission 2016). We can therefore consider that the experimental conditions were valid for evaluating the effectiveness of the products tested.
The inhibition of the production of the four mycotoxins was found to be directly proportional to the amount of NPV, Mycofix and clays. According to Grant et al (1998) and Asghar et al (2015) there is a dose-response relationship between the adsorbent and adsorbate.
The results of the present study are in agreement with this finding. Our results show that the NPV at the dose of 1 g kg-1 and 2 g kg-1 has a superior efficiency compared to Mycofix and non-activated clays whatever the mycotoxin metered. The advantage of NPV is that it exerts its inhibitory action on the production of mycotoxins in the lowest tested concentration which is 1 g kg-1, while other products have a similar activity only when the dose reaches 4 g kg-1. This may be explained by the combination of the antifungal action of the essential oils with the binder effect of clay minerals.
The authors are deeply grateful to Miss Imane Remmal, Soukaina Remmal and Mrs Hélène Mock for their assistance in checking the English of the manuscript.
Alshannaq A and Yu J H 2017 Occurrence, toxicity, and analysis of major mycotoxins in food. International journal of environmental research and public health, 14(6): 632. https://www.mdpi.com/1660-4601/14/6/632/htm
Asghar M A, Iqbal J, Ahmed A, Inam M, Khan M A and Jameel K 2015 In vitro aflatoxins adsorption by silicon dioxide in naturally contaminated maize (Zea mays L.) and compared with activated charcoal. Research Journal of Agriculture and Biological Sciences, 11(3): 9-16.
Befikadu D 2014 Factors affecting quality of grain stored in Ethiopian traditional storage structure and opportunities for improvement. International Journal of Basic and Applied Sciences, 18(1): 235-257.
Bluma R V and Etcheverry M G 2008 Application of essential oils in maize grain: Impact on Aspergillus section Flavi growth parameters and aflatoxin accumulation. Food Microbiology, 25(2): 324-334.
Boisen S and Fernández J A 1997 Prediction of the total tract digestibility of energy in feedstuffs and pig diets by in vitro analyses. Animal Feed Science and Technology, 68(3-4): 277-286.
Boudine L, Louaste B, Eloutassi N, Chami N, Chami F and Remmal A 2016 Antifungal activity of oregano essential oil and thymol against some fungi isolated from corn grains. International Journal of Innovation and Applied Studies, 17(4): 1120. https://pdfs.semanticscholar.org/336a/1a1aaa6bf2c3a3ae35787020fd27817791b3.pdf
Boukaew S, Prasertsan P and Sattayasamitsathit S 2017 Evaluation of antifungal activity of essential oils against aflatoxigenic Aspergillus flavus and their allelopathic activity from fumigation to protect maize seeds during storage. Industrial crops and product, 97: 558-566.
European Commission 2016 Commission Recommendation 2016/1319 of 29 July 2016 amending Recommendation 2006/576/EC as regards deoxynivalenol, zearalenone and ochratoxin A in pet food. Offcial Journal of European Union 58–60. https://eur-lex.europa.eu/legal-content/EN/TXT/PDF/?uri=CELEX:32016H1319&from=EN
European Union 2013 Commission Implementing Regulation (EU) No 1060/2013 of 29 October 2013 Concerning the Authorisation of Bentonite as a Feed Additive for all Animal Species. https://eur-lex.europa.eu/LexUriServ/LexUriServ.do?uri=OJ:L:2013:289:0033:0037:EN:PDF
Geary P A, Chen G, Kimanya M E, Shirima, Oplatowska-Stachowiak E, and Gong C T 2016 Determination of multi-mycotoxin occurrence in maize based porridges from selected regions of Tanzania by liquid chromatography tandem mass spectrometry (LC-MS/MS), a longitudinal study. Food Control, 68: 337-343.
Grant P G and Phillips T D 1998 Isothermal adsorption of aflatoxin B1 on HSCAS clay. Journal of agricultural and food chemistry, 46(2): 599-605.
Kolosova A and Stroka J 2011 Substances for reduction of the contamination of feed by mycotoxins : A review. World Mycotoxin Journal, 4(3): 225–256.
Kong C, Shin S Y and Kim B G 2014 Evaluation of mycotoxin sequestering agents for aflatoxin and deoxynivalenol: an in vitro approach. SpringerPlus, 3(1): 346. https://springerplus.springeropen.com/track/pdf/10.1186/2193-1801-3-346
Mahmood T, Pasha T N and Khattak F M 2011 Comparative Evaluation of Different Techniques for Aflatoxin Detoxification in Poultry Feed and Its Effect on Broiler Performance. In Aflatoxins-Detection, Measurement and Control. InTech.
Murugesan G R, Ledoux D R, Naehrer K, Berthiller F, Applegate T J, Grenier B and Schatzmayr G 2015 Prevalence and effects of mycotoxins on poultry health and performance, and recent development in mycotoxin counteracting strategies. Poultry science, 94(6):1298-1315. https://academic.oup.com/ps/article/94/6/1298/1562119
Mylona K 2012 Fusarium species in grains: dry matter losses, mycotoxin contamination and control strategies using ozone and chemical compounds. PhD thesis. Cranfield university England. https://dspace.lib.cranfield.ac.uk/bitstream/handle/1826/7876/Kalliopi_Mylona_Thesis_2012.pdf?sequence=1&isAllowed=y
Romer Labs 2002 Romer Labs Methods, Method: PI-000051-1: total aflatoxin. http://www.autoprep.jp/kosou/pdf/AgraQuant%20Afla%20Method_1-20_020108.pdf
Romer Labs 2003 Romer Labs Methods, Method: PI-000094-1: toxin T-2. http://www.autoprep.jp/kosou/pdf/AgraQuant%20T-2%20Method_020108.pdf
Romer Labs 2007a Romer Labs Methods, Method: PI-000082-1: total fumonisin. http://www.autoprep.jp/kosou/pdf/AgraQuant%20FUM%20Method%20_0.25-5_010108.pdf
Romer Labs 2007b Romer Labs Methods, Method: PI-000083-1: DON. http://www.autoprep.jp/kosou/pdf/AgraQuant%20DON%20Method_020108.pdf
Schatzmayr G, Zehner F, Taubel M, Schatmayr D, Klimitsch A, Loibner A P and Binder E M 2006 Microbiologicals for deactivating mycotoxins. Molecular Nutrition and Food Research, 50(6): 543–551.
Udomkun P, Wiredu A N, Nagle M, Bandyopadhyay R, Müller J and Vanlauwe B 2017 Mycotoxins in Sub-Saharan Africa: Present situation, socio-economic impact, awareness, and outlook. Food Control, 72: 110-122.
Yiannikouris A and Jouany J P 2002 Mycotoxins in feeds and their fate in animals: a review. Animal Research, 51(2): 81-99. https://animres.edpsciences.org/articles/animres/abs/2002/02/01/01.html
Yiannikouris A 2004 Etude des mécanismes chimiques impliqueés dans la complexation de mycotoxines par les composants de la paroi cellulaire de la levure Saccharomyce scerevisiae. Clermont Ferrand, France: Blaise Pascal University, MSc thesis. https://www.theses.fr/2004CLF21512
Received 12 December 2018; Accepted 9 February 2019; Published 4 March 2019